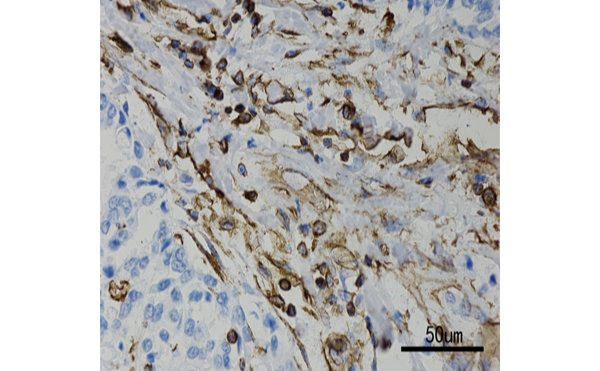

慢病毒感染增强试剂盒
- OmL-04
- 上海睿远生物
- 上海市
- 一周内
- 30Tests盒
- 646 元
- 2022-05-23 14:23:10
上海睿远生物医药科技有限公司
慢病毒感染增强试剂盒

一、运输与存储条件。
本产品低温运输,各组份根据保存条件分开保存,有效期 12 个月。
二、注意事项(请使用试剂盒前阅读此注意事项)。
1. Reagent A 和 Reagent C 置于 4 ℃保存,严禁冻存,否则失效。
2. Reagent B 在-80 ℃保存 12 个月,-20 ℃保存 1 个月。
3. 请使用慢病毒滴度高的细胞培养上清,或纯化的慢病毒溶液,感染细胞,保证实验效果。慢 病毒滴度较低时感染增强效果不明显。
4. 感染慢病毒时,细胞密度保持在 70%以下,细胞密度太大不利于慢病毒感染。
5. 本说明书中所列的各种试剂用量在大部分细胞株中具有很好的感染增强效果,且没有细胞毒 性。若在特定细胞中出现细胞毒性,请按比例缩减各种试剂的用量。
6. 为了避免细胞毒性,各试剂可以按比例缩小用量。
7. 说明书中所列的各种试剂的用量为 2 ml 培养体系中的试剂用量,若用于培养皿(直径 100 mm 的培养皿,培养液为 10 ml)等大培养体系时,请根据具体的培养体系按比例增加各试剂用量。 8. 本产品为无菌包装,使用时请注意保持无菌状态,以免导致细胞污染。
三、产品简介。 本产品是一款旨在增强慢病毒感染效果的试剂,与经典的慢病毒感染增强试剂 Polybrene 相比, 感染效率提高 4-8 倍。
四、特点与优势。 1. 本产品在多种细胞株中能够增强慢病毒的感染效果。 2. 本产品对大多数细胞没有毒性。
五、使用说明。
- 细胞培养。将细胞接种到 6 孔培养板,2 ml/孔,24 h 后细胞密度为 30-70%。(细胞密度太大不 利于病毒感染,细胞密度请尽量保持在 70%以下)
- 慢病毒感染增强试剂处理。准备无菌 EP 管(1.5 ml),加入 946 μl 细胞培养液,2 μl Reagent A、 2 μl Reagent B、50 μl Reagent C,混匀。
- 移除 6 孔培养板中的培养液,加入 1 ml 混合慢病毒感染增强试剂的培养液。
- 慢病毒感染。将含有慢病毒的细胞培养上清加入 6 孔细胞培养板,1 ml/孔,与先前加入的含有 慢病毒感染增强试剂的培养液混合,保持 2 ml/孔的培养体系,CO2培养箱中继续培养。
- 换液。慢病毒感染 24 h 后,更换成新鲜培养液,继续培养 48 h。中间若细胞生长较快,应根据 细胞生长情况和培养液颜色变化随时更换细胞培养液,保证良好的细胞生长状态。
- 检测。慢病毒感染 72 h,利用荧光显微镜检测绿色荧光蛋白(GFP)表达情况,判断慢病毒感 染效果,或利用其他技术检测目的蛋白表达水平。